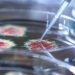
Mikropların var olduğuna inanmayan insanlar

Hakan Çalhanoğlu, Inter’in Empoli’yi 1-0 mağlup ettiği maçtaki performansıyla İtalyan medyasından övgü dolu yorumlar aldı.
Hakan Çalhanoğlu, Empoli maçındaki performansıyla övgülerin odağında.
İtalya Serie A’nın 5. hafta maçında Empoli, Inter’i konuk etti. Misafir takım, Federico Dimarco’nun 51. dakikada attığı golle rakibini 1-0 mağlup ederken, Inter’in Türk futbolcusu Hakan Çalhanoğlu da karşılaşmaya damgasını vuran isimlerden birisi oldu.
Müsabakaya ilk 11’de başlayan ve 90 dakika sahada kalan Hakan Çalhanoğlu, başarılı performansının ardından İtalyan basınından övgü dolu yorumlar aldı. La Gazzetta dello Sport’a göre Türk futbolcu, Dimarco ile birlikte maçın en iyi oyuncuları arasındaydı.
“Maçın temposunu Çalhanoğlu belirledi”
Hafif sakatlığının ardından sahalara dönen 29 yaşındaki oyuncu için, “Her zamankinden daha dinç görünüyordu. Çalhanoğlu kaleyi bulamamış olabilir ama geri kalan her şeyi yaptı. Inter’in hem toplu hem topsuz oyununda her şeyin merkezinde o vardı. Maçın temposunu o belirledi” ifadeleri kullanıldı.
5 maçta 2 gol
Bu sezon Serie A’da 5 maça çıkan Hakan Çalhanoğlu, 428 dakika sahada kalırken 2 kez fileleri havalandırdı.
***Mutluluk, adalet, özgürlük, hukuk, insanlık ve sevgi paylaştıkça artar***